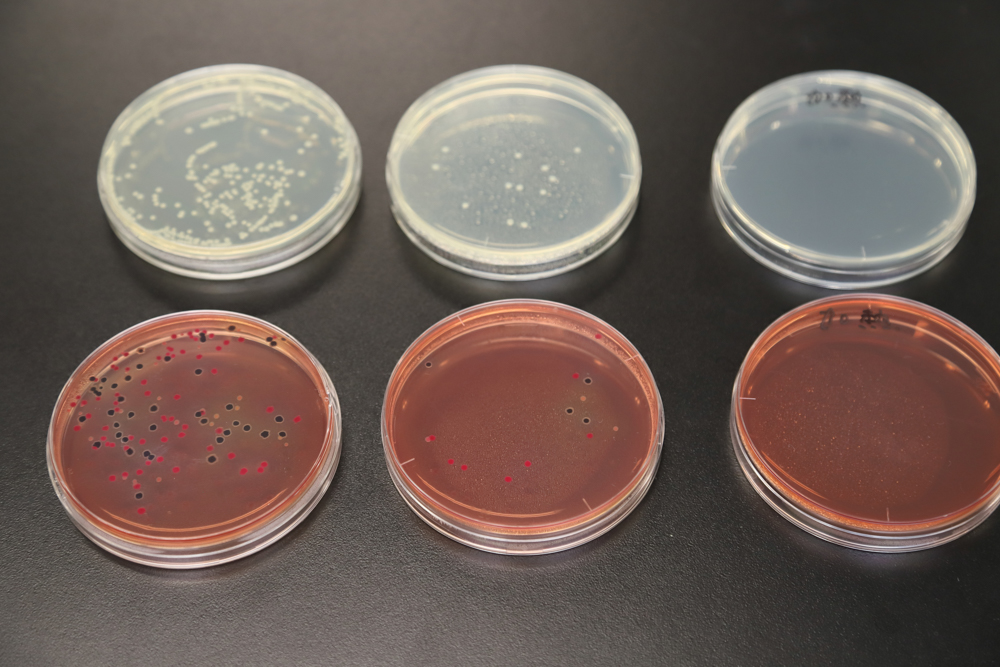

「獣医師をめざす中高生のための体験セミナー」同行取材
2025年12月20日 会場;山口大学共同獣医学部

山口大学共同獣医学部において2025年12月20日(土)、中高生のための体験セミナーが開催されました。獣医師に興味を持つ生徒の参考にと、玖西食肉加工事業協同組合(産業)と山口大学同学部(学)そして岩国市(官)の産学官が連携して開催したもの。昨年に続いて2回目の開催でした。
参加したのは生徒8名(高校生2名、中学生6名)とその保護者2名。午前10時から昼休みをはさんで午後3時までの体験セミナーに、同行取材しました。
イヌ・ネコだけじゃない、獣医師の仕事

度会雅久学部長から、共同獣医学部や獣医師の仕事内容についての説明がありました。
山口大学は鹿児島大学と共同で運営されています。そのため、最新の通信システムによって授業が共有されています。また、感染症に関する研究設備が充実し、その研究も盛んにおこなわれています。これを学ぶため、海外からも多くの留学生を受け入れているとのこと。学生には専門知識や技術の習得はもちろん、コミュニケーション能力が求められるとの話でした。
また、獣医師が活躍する分野は多岐にわたり、これには参加した生徒も驚いた様子でした。一般的にはイヌ・ネコなどの動物病院が思い当たるところですが、実は獣医師は食品衛生に関わる分野において欠かせない職種です。例えば県庁等の公務員として畜産業を支えたり、畜産業はもとより食品関連企業からも求人が多くあるとのことです。
しかし、学生のおよそ半数は動物病院を就職先に選んでいるのが現実です。そのため畜産業における獣医師不足は深刻度を増しています。今回の体験セミナー開催についても、「この問題の克服に少しでも役立ってくれたら」という切実な思いがあると、岩国市の職員は打ち明けてくれました。
動物の模型に興奮
渡邉健太准教授の案内で、学内施設を見学しました。獣医学国際教育研究センター(通称iCOVER)の各階を巡り、当学部の特長の一つである高度な感染症研究の実験室をガラス越しに見学しました。
また、本館の実習室では、様々な動物の模型を目にして、実際に触ることができました。犬の心音による診察では、様々な病気のパターンが再現され、その違いを確かめることができました。

さらに、牛のモデルでは、直腸に手を入れて子宮の模型を触診したり、分娩時の子牛の体重と同じ重さの模型を抱いて、その重さに驚いたり。これには、生徒だけでなく大人も興奮した様子でした。

手術を仮想体験

清水 隆准教授の指導のもと、参加者はVRゴーグルを装着して、手術の見学を行いました。手術室に立ち、360度を見渡しながら、目の前で繰り広げられる子宮摘出手術を、映像を通じて見学しました。参加者たちは顔を右に左に動かしながら、その映像にくぎ付けでした。
学部の学生は、診療の現場に出向く前に、このVRによって予習をして、現場に慣れるのだそうです。映像は清水准教授が撮影して編集したもの。VR撮影のための特殊なカメラも見せていただきました。
細菌検査に挑戦

参加者は白衣に着替えてマスクと手袋を装着。病原体から研究者を守る安全キャビネットに手を入れて、細菌の検査を体験しました。ハンバーグの肉の焼く前と後では細菌の数や種類はどうなっているのか。渡邉准教授によるスライドを使っての説明を聞き、いざ、実験です。


獣医学部の学生の指導も受けながらも、安全キャビネットで器具を片手に検体に向かう姿はさながら研究者そのもの。中学生の保護者は、「え~、本物の研究者みたい!」と我が子に目を細めていました。
実験結果を知るためには、時間が足らないため、前日に大学で仕込まれたものを観察しました。火を入れていない肉には様々な色の斑点があり、それらが病原性大腸菌なのだと知りました。その斑点の色によって菌の種類がわかるとのこと。たくさんある黒色の斑点はサルモネラ菌です。
なお、実験結果がわかりやすいように、検体にはわざと多めに細菌を入れてあるとのこと。実際には、日本の精肉にこれほどの細菌はないそうです。
獣医学部生の「生の声」を聞く

体験セミナーの最後には、獣医学部の学生との対談が用意されていました。各テーブルに一人、学生が入って、対談というより、談笑が始まりました。
「競馬の業界に入りたいんですが…」と参加者が尋ねると、「その場合だと、大動物の研究室に入ればいいよね」と学生が答えます。なぜ競馬なのかと逆に聞いてみると、「給料がいいって聞きました」と参加者。学生も納得の様子でした。
参加者のなかには、「魚が好きで、海獣医師になりたい」という中学生もあり、学部生から魚の勉強もできると聞いて興味津々の表情。聞けばその中学生は、小学4年の頃から魚の学者になりたいと思っていたのだとか。
約30分間の対談はあっという間に過ぎました。指導にあたった渡邉准教授によると、「去年より対談が盛り上がって、とても良かった」とのことでした。
獣医師への興味が増しました!
「VRが面白かった」という意見と共に、多かったのは「実習が楽しかった」という感想でした。専門的な器具を使っての実験に「わくわくした」という生徒もあれば、「普段食べているものにも、色々な細菌がいることに驚いた」との声もありました。
また、「獣医師がどんな仕事に就いているのかを知ることができて、とてもためになった」との声もありました。
話を聞くことのできた生徒の全員が、「獣医師への興味が増した」と答えてくれました。
地元から獣医師を!
この体験セミナーの主催者の一人、玖西食肉加工事業協同組合の理事長を務める安堂卓也さん(安堂畜産株式会社・代表取締役)はこの催しに対する思いをこう語ります。
「岩国市の高森地区は明治から続く牛肉の産地です。この地元から獣医師が誕生して、できればこの地域の畜産業を担う人材になってくれることを願っています」
今回参加した生徒たちが、この体験をきっかけの一つとし、獣医学部に入学することを産学官連携の主催者たちは切に願っています。そして、獣医師として地元に貢献してくれる。そんな成果を生み出すには、最短でも大学入学から6年を要する地道な活動です。
体験セミナーは来年も、この山口大学で行われる予定です。
